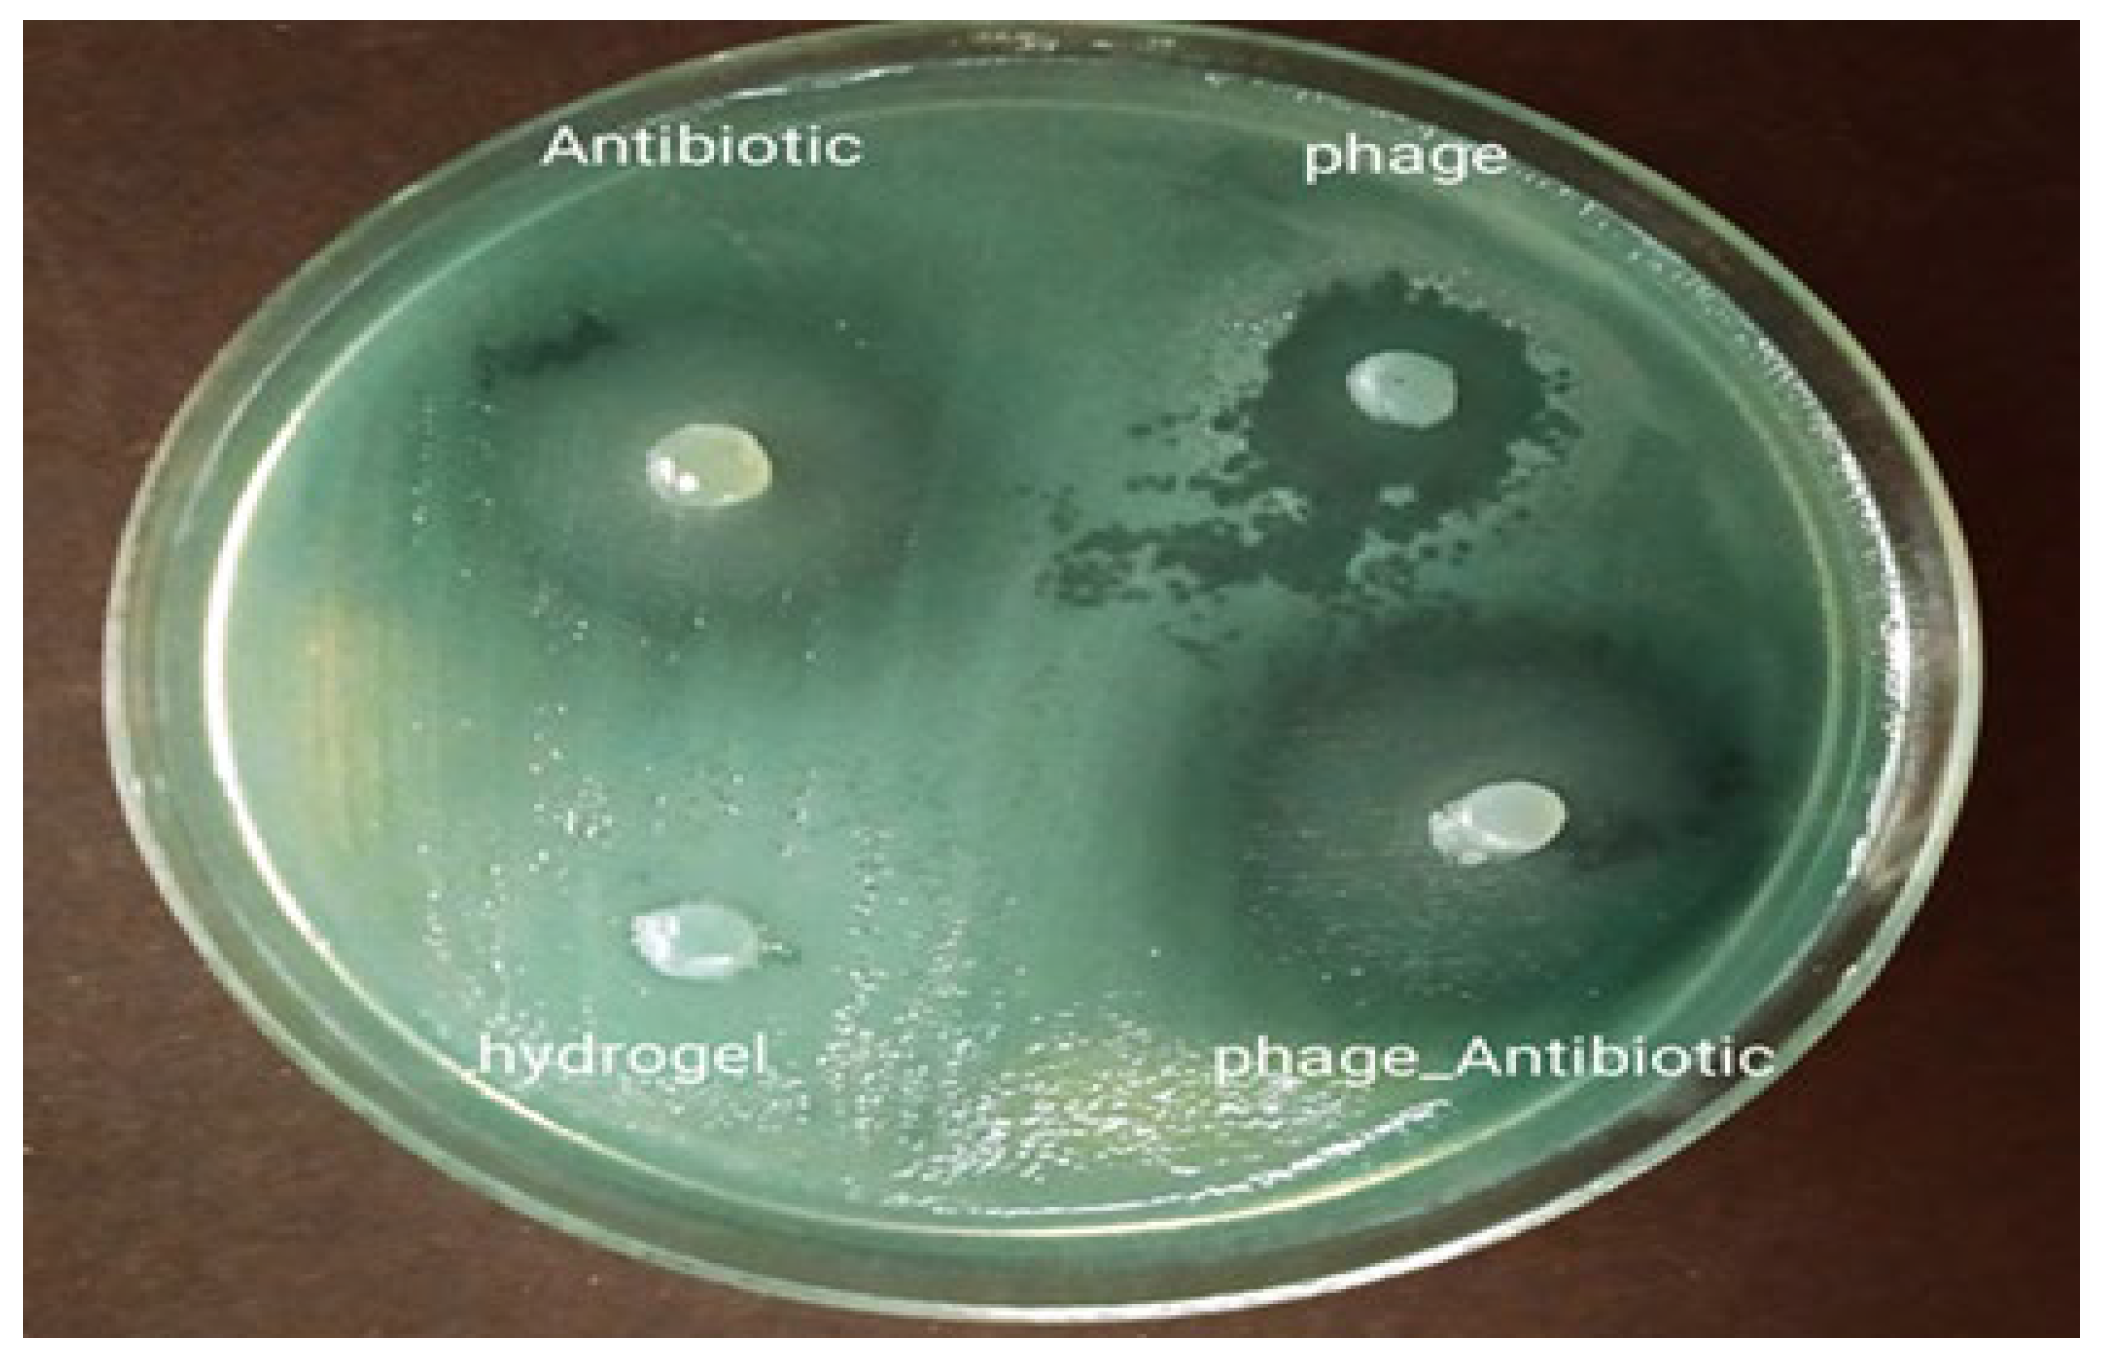
Viruses 15 00803 g009 Viruses 15 00803 g009

Design of Phage-Cocktail–Containing Hydrogel for the Treatment of Pseudomonas aeruginosa–Infected Wounds
Abstract
1. Introduction
2. Materials and Methods
2.1. Materials
2.2. Determining the Pattern of Antibiotic Susceptibility
2.3. Preparation of Phages
2.3.1. Isolation of Bacteriophages
2.3.2. Purification and Storage of Bacteriophage
2.3.3. Bacteriophage Titration
2.3.4. Bacteriophage Host Range
2.3.5. Transmission Electron Microscopy (TEM)
2.3.6. Phage Genome Sequencing
2.4. Preparation of Hydrogel
2.5. Preparation of Bacteriophages and Ciprofloxacin Encapsulated in SA-CMC Hydrogels
2.6. Characterisation of the SA-CMC Hydrogels
2.6.1. Determination of the Swelling Index
2.6.2. Degradation of Hydrogels
2.6.3. Water Vapor Transmission Rate
2.6.4. Scanning Electron Microscopy (SEM) Analysis
2.6.5. Fourier Transform Infrared (FTIR) Spectroscopy
2.6.6. In Vitro Antibacterial Activity Assay
2.6.7. Stability Studies
2.7. Animal Experiments
2.7.1. Wound Formation and Infection Model
2.7.2. In Vivo Evaluation of Antibacterial Effect of Hydrogel
2.7.3. Wound Healing
2.7.4. Blood Cultures of Dead Mice
2.7.5. Histopathological Studies
2.7.6. Statistical Analysis
3. Results and Discussion
3.1. Antibiotic Susceptibility Pattern
3.2. Characterization of Bacteriophages
3.3. Phage Genome Characterization
3.4. Preparation and Characterization of Hydrogels
3.4.1. Swelling Index Analysis
3.4.2. In Vitro Degradation Behavior of Dressing
3.4.3. Water Vapor Transfer Rate of Hydrogels
3.4.4. FTIR Analysis
3.4.5. Hydrogel Surface Morphology
3.5. In Vitro Antibacterial Activity Assays
3.6. Stability of the Antibacterial Efficiency of the Hydrogels
3.7. Animal Experiments
3.7.1. In Vivo Antibacterial Activity
3.7.2. Wound Healing
3.7.3. Histopathological Studies
4. Conclusions
Author Contributions
Funding
Institutional Review Board Statement
Informed Consent Statement
Data Availability Statement
Acknowledgments
Conflicts of Interest
References
- Tottoli, E.M.; Dorati, R.; Genta, I.; Chiesa, E.; Pisani, S.; Conti, B. Skin Wound Healing Process and New Emerging Technologies for Skin Wound Care and Regeneration. Pharmaceutics 2020, 12, 735. [Google Scholar] [CrossRef] [PubMed]
- Negut, I.; Grumezescu, V.; Grumezescu, A.M. Treatment Strategies for Infected Wounds. Molecules 2018, 23, 2392. [Google Scholar] [CrossRef] [PubMed]
- Bassetti, M.; Vena, A.; Croxatto, A.; Righi, E.; Guery, B. How to Manage Pseudomonas Aeruginosa Infections. Drugs Context 2018, 7, 212527. [Google Scholar] [CrossRef] [PubMed]
- Pang, Z.; Raudonis, R.; Glick, B.R.; Lin, T.J.; Cheng, Z. Antibiotic Resistance in Pseudomonas Aeruginosa: Mechanisms and Alternative Therapeutic Strategies. Biotechnol. Adv. 2019, 37, 177–192. [Google Scholar] [CrossRef]
- Botelho, J.; Grosso, F.; Peixe, L. Antibiotic Resistance in Pseudomonas Aeruginosa—Mechanisms, Epidemiology and Evolution. Drug Resist. Updates 2019, 44, 100640. [Google Scholar] [CrossRef]
- Górski, A.; Międzybrodzki, R.; Węgrzyn, G.; Jończyk-Matysiak, E.; Borysowski, J.; Weber-Dąbrowska, B. Phage Therapy: Current Status and Perspectives. Med. Res. Rev. 2020, 40, 459–463. [Google Scholar] [CrossRef]
- Al-Ishaq, R.K.; Skariah, S.; Büsselberg, D. Bacteriophage Treatment: Critical Evaluation of Its Application on World Health Organization Priority Pathogens. Viruses 2021, 13, 51. [Google Scholar] [CrossRef]
- Melo, L.D.R.; Oliveira, H.; Pires, D.P.; Dabrowska, K.; Azeredo, J. Phage Therapy Efficacy: A Review of the Last 10 Years of Preclinical Studies. Crit. Rev. Microbiol. 2020, 46, 78–99. [Google Scholar] [CrossRef]
- Lin, D.M.; Koskella, B.; Lin, H.C. Phage Therapy: An Alternative to Antibiotics in the Age of Multi-Drug Resistance. World J. Gastrointest. Pharmacol. Ther. 2017, 8, 162. [Google Scholar] [CrossRef]
- Kim, H.Y.; Chang, R.Y.K.; Morales, S.; Chan, H.K. Bacteriophage-Delivering Hydrogels: Current Progress in Combating Antibiotic Resistant Bacterial Infection. Antibiotics 2021, 10, 130. [Google Scholar] [CrossRef]
- Lin, Y.; Quan, D.; Chang, R.Y.K.; Chow, M.Y.T.; Wang, Y.; Li, M.; Morales, S.; Britton, W.J.; Kutter, E.; Li, J.; et al. Synergistic Activity of Phage PEV20-Ciprofloxacin Combination Powder formulation—A Proof-of-Principle Study in a P. Aeruginosa Lung Infection Model. Eur. J. Pharm. Biopharm. 2021, 158, 166–171. [Google Scholar] [CrossRef] [PubMed]
- Moghadam, M.T.; Amirmozafari, N.; Shariati, A.; Hallajzadeh, M.; Mirkalantari, S.; Khoshbayan, A.; Jazi, F.M. How Phages Overcome the Challenges of Drug Resistant Bacteria in Clinical Infections. Infect. Drug Resist. 2020, 13, 45–61. [Google Scholar] [CrossRef]
- Abedon, S.T.; Danis-Wlodarczyk, K.M.; Wozniak, D.J. Phage Cocktail Development for Bacteriophage Therapy: Toward Improving Spectrum of Activity Breadth and Depth. Pharmaceuticals 2021, 14, 1019. [Google Scholar] [CrossRef]
- Rotman, S.G.; Sumrall, E.; Ziadlou, R.; Grijpma, D.W.; Richards, R.G.; Eglin, D.; Moriarty, T.F. Local Bacteriophage Delivery for Treatment and Prevention of Bacterial Infections. Front. Microbiol. 2020, 11, 538060. [Google Scholar] [CrossRef] [PubMed]
- Barros, J.A.R.; de Melo, L.D.R.; da Silva, R.A.R.; Ferraz, M.P.; de Azeredo, J.C.V.R.; de Pinheiro, V.M.C.; Colaço, B.J.A.; Fernandes, M.H.R.; de Gomes, P.S.; Monteiro, F.J. Encapsulated Bacteriophages in Alginate-Nanohydroxyapatite Hydrogel as a Novel Delivery System to Prevent Orthopedic Implant-Associated Infections. Nanomed. Nanotechnol. Biol. Med. 2020, 24, 102145. [Google Scholar] [CrossRef]
- Narayanaswamy, R.; Torchilin, V.P. Hydrogels and Their Applications in Targeted Drug Delivery. Molecules 2019, 24, 603. [Google Scholar] [CrossRef] [PubMed]
- Pérez-Luna, V.H.; González-Reynoso, O. Encapsulation of Biological Agents in Hydrogels for Therapeutic Applications. Gels 2018, 4, 61. [Google Scholar] [CrossRef]
- Zhang, J.; Ge, J.; Xu, Y.; Chen, J.; Zhou, A.; Sun, L.; Gao, Y.; Zhang, Y.; Gu, T.; Ning, X. Bioactive Multi-Engineered Hydrogel Offers Simultaneous Promise against Antibiotic Resistance and Wound Damage. Int. J. Biol. Macromol. 2020, 164, 4466–4474. [Google Scholar] [CrossRef]
- Kaur, P.; Gondil, V.S.; Chhibber, S. A Novel Wound Dressing Consisting of PVA-SA Hybrid Hydrogel Membrane for Topical Delivery of Bacteriophages and Antibiotics. Int. J. Pharm. 2019, 572, 118779. [Google Scholar] [CrossRef]
- Humphries, R.M.; Abbott, A.N.; Hindler, J.A. Understanding and Addressing CLSI Breakpoint Revisions: A Primer for Clinical Laboratories. J. Clin. Microbiol. 2019, 57, e00203–e00219. [Google Scholar] [CrossRef]
- Clokie, M.R.J.; Kropinski, A.M. Bacteriophages: Methods and Protocols; Humana Press: Clifton, NJ, USA, 2009; ISBN 9781588296825 (hbk.). r1588296822 (hbk.). [Google Scholar]
- Rahimzadeh, G.; Gill, P.; Rezai, M.S. Characterization and Lytic Activity of Methicillin-Resistant Staphylococcus aureus (MRSA) Phages Isolated from NICU. Australas. Med. J. 2016, 9, 169–175. [Google Scholar] [CrossRef]
- Rahimzadeh, G.; Saeedi, M.; Moosazadeh, M.; Hashemi, S.M.H.; Babaei, A.; Rezai, M.S.; Kamel, K.; Asare-Addo, K.; Nokhodchi, A. Encapsulation of Bacteriophage Cocktail into Chitosan for the Treatment of Bacterial Diarrhea. Sci. Rep. 2021, 11, 15603. [Google Scholar] [CrossRef] [PubMed]
- Coil, D.; Jospin, G.; Darling, A.E. A5-Miseq: An Updated Pipeline to Assemble Microbial Genomes from Illumina MiSeq Data. Bioinformatics 2015, 31, 587–589. [Google Scholar] [CrossRef] [PubMed]
- Garneau, J.R.; Depardieu, F.; Fortier, L.C.; Bikard, D.; Monot, M. PhageTerm: A Tool for Fast and Accurate Determination of Phage Termini and Packaging Mechanism Using next-Generation Sequencing Data. Sci. Rep. 2017, 7, 8292. [Google Scholar] [CrossRef] [PubMed]
- Aziz, R.K.; Bartels, D.; Best, A.; DeJongh, M.; Disz, T.; Edwards, R.A.; Formsma, K.; Gerdes, S.; Glass, E.M.; Kubal, M.; et al. The RAST Server: Rapid Annotations Using Subsystems Technology. BMC Genom. 2008, 9, 75. [Google Scholar] [CrossRef] [PubMed]
- Carver, T.; Harris, S.R.; Berriman, M.; Parkhill, J.; McQuillan, J.A. Artemis: An Integrated Platform for Visualization and Analysis of High-Throughput Sequence-Based Experimental Data. Bioinformatics 2012, 28, 464–469. [Google Scholar] [CrossRef]
- Yang, X.; Liu, Q.; Chen, X.; Yu, F.; Zhu, Z. Investigation of PVA/ws-Chitosan Hydrogels Prepared by Combined γ-Irradiation and Freeze-Thawing. Carbohydr. Polym. 2008, 73, 401–408. [Google Scholar] [CrossRef]
- Zhou, M.; Lin, F.; Li, W.; Shi, L.; Li, Y.; Shan, G. Development of Nanosilver Doped Carboxymethyl Chitosan-Polyamideamine Alginate Composite Dressing for Wound Treatment. Int. J. Biol. Macromol. 2021, 166, 1335–1351. [Google Scholar] [CrossRef]
- Jumaa, M.; Furkert, F.H.; Müller, B.W. A New Lipid Emulsion Formulation with High Antimicrobial Efficacy Using Chitosan. Eur. J. Pharm. Biopharm. 2002, 53, 115–123. [Google Scholar] [CrossRef]
- Cardiff, R.D.; Miller, C.H.; Munn, R.J. Manual Hematoxylin and Eosin Staining of Mouse Tissue Sections. Cold Spring Harb. Protoc. 2014, 2014, 655–658. [Google Scholar] [CrossRef]
- Rahimzadeh, G.; Saeedi, M.; Farshidi, F.; Rezai, M.S. Phage Therapy in Treatment of Gram-Negative Bacterial Infections: A Systematic Review. J. Maz. Univ. Med. Sci. 2018, 28, 203–212. [Google Scholar]
- Alves, D.R.; Perez-Esteban, P.; Kot, W.; Bean, J.E.; Arnot, T.; Hansen, L.H.; Enright, M.C.; Jenkins, A.T.A. A Novel Bacteriophage Cocktail Reduces and Disperses Pseudomonas Aeruginosa Biofilms under Static and Flow Conditions. Microb. Biotechnol. 2016, 9, 61–74. [Google Scholar] [CrossRef] [PubMed]
- Ceyssens, P.J.; Lavigne, R. Bacteriophages of Pseudomonas. Future Microbiol. 2010, 5, 1041–1055. [Google Scholar] [PubMed]
- Essoh, C.; Latino, L.; Midoux, C.; Blouin, Y.; Loukou, G.; Nguetta, S.P.A.; Lathro, S.; Cablanmian, A.; Kouassi, A.K.; Vergnaud, G.; et al. Investigation of a Large Collection of Pseudomonas Aeruginosa Bacteriophages Collected from a Single Environmental Source in Abidjan, Côte d’Ivoire. PLoS ONE 2015, 10, e0130548. [Google Scholar] [CrossRef] [PubMed]
- Krupovic, M.; Turner, D.; Morozova, V.; Dyall-Smith, M.; Oksanen, H.M.; Edwards, R.; Dutilh, B.E.; Lehman, S.M.; Reyes, A.; Baquero, D.P.; et al. Bacterial Viruses Subcommittee and Archaeal Viruses Subcommittee of the ICTV: Update of Taxonomy Changes in 2021. Arch. Virol. 2021, 166, 3239–3244. [Google Scholar] [CrossRef]
- Malik, D.J.; Sokolov, I.J.; Vinner, G.K.; Mancuso, F.; Cinquerrui, S.; Vladisavljevic, G.T.; Clokie, M.R.J.; Garton, N.J.; Stapley, A.G.F.; Kirpichnikova, A. Formulation, Stabilisation and Encapsulation of Bacteriophage for Phage Therapy. Adv. Colloid Interface Sci. 2017, 249, 100–133. [Google Scholar] [CrossRef]
- Caló, E.; Khutoryanskiy, V.V. Biomedical Applications of Hydrogels: A Review of Patents and Commercial Products. Eur. Polym. J. 2015, 65, 252–267. [Google Scholar] [CrossRef]
- Jacob, S.; Nair, A.B.; Shah, J.; Sreeharsha, N.; Gupta, S.; Shinu, P. Emerging Role of Hydrogels in Drug Delivery Systems, Tissue Engineering and Wound Management. Pharmaceutics 2021, 13, 357. [Google Scholar] [CrossRef]
- Fan, Z.; Liu, B.; Wang, J.; Zhang, S.; Lin, Q.; Gong, P.; Ma, L.; Yang, S. A Novel Wound Dressing Based on Ag/graphene Polymer Hydrogel: Effectively Kill Bacteria and Accelerate Wound Healing. Adv. Funct. Mater. 2014, 24, 3933–3943. [Google Scholar] [CrossRef]
- Zhou, Q.; Kang, H.; Bielec, M.; Wu, X.; Cheng, Q.; Wei, W.; Dai, H. Influence of Different Divalent Ions Cross-Linking Sodium Alginate-Polyacrylamide Hydrogels on Antibacterial Properties and Wound Healing. Carbohydr. Polym. 2018, 197, 292–304. [Google Scholar] [CrossRef]
- Dorati, R.; De Trizio, A.; Genta, I.; Merelli, A.; Modena, T.; Conti, B. Gentamicin-Loaded Thermosetting Hydrogel and Moldable Composite Scaffold: Formulation Study and Biologic Evaluation. J. Pharm. Sci. 2017, 106, 1596–1607. [Google Scholar] [CrossRef] [PubMed]
- Zhang, K.; Wang, Y.; Wei, Q.; Li, X.; Guo, Y.; Zhang, S. Design and Fabrication of Sodium Alginate/carboxymethyl Cellulose Sodium Blend Hydrogel for Artificial Skin. Gels 2021, 7, 115. [Google Scholar] [CrossRef] [PubMed]
- Klunklin, W.; Jantanasakulwong, K.; Phimolsiripol, Y.; Leksawasdi, N.; Seesuriyachan, P.; Chaiyaso, T.; Insomphun, C.; Phongthai, S.; Jantrawut, P.; Sommano, S.R.; et al. Synthesis, Characterization, and Application of Carboxymethyl Cellulose from Asparagus Stalk End. Polymers 2021, 13, 81. [Google Scholar] [CrossRef] [PubMed]
- Lin, Y.; Chang, R.Y.K.; Britton, W.J.; Morales, S.; Kutter, E.; Chan, H.K. Synergy of Nebulized Phage PEV20 and Ciprofloxacin Combination against Pseudomonas Aeruginosa. Int. J. Pharm. 2018, 551, 158–165. [Google Scholar] [CrossRef]




 Based on the analysis of Figure 5A, hydrogel swelling on day 5 is significant with the rest of the days (p < 0.001) and the day 1 is significant with the rest of the days, except for day 2, at the level of p < 0.05. Moreover, day 2 is significant with day 4 (p < 0.05).
Based on the analysis of Figure 5A, hydrogel swelling on day 5 is significant with the rest of the days (p < 0.001) and the day 1 is significant with the rest of the days, except for day 2, at the level of p < 0.05. Moreover, day 2 is significant with day 4 (p < 0.05).
 Based on the analysis of Figure 5A, hydrogel swelling on day 5 is significant with the rest of the days (p < 0.001) and the day 1 is significant with the rest of the days, except for day 2, at the level of p < 0.05. Moreover, day 2 is significant with day 4 (p < 0.05).
Based on the analysis of Figure 5A, hydrogel swelling on day 5 is significant with the rest of the days (p < 0.001) and the day 1 is significant with the rest of the days, except for day 2, at the level of p < 0.05. Moreover, day 2 is significant with day 4 (p < 0.05).

The statistical analysis of the five groups in all the tested hours indicated a significant difference between the two control and hydrogel groups with the other three groups at the level of p < 0.01.
The statistical analysis of the five groups in all the tested hours indicated a significant difference between the two control and hydrogel groups with the other three groups at the level of p < 0.01.
 The statistical analysis of the five groups in all the tested hours indicated a significant difference between the two control and hydrogel groups with the other three groups at the level of p < 0.01.
The statistical analysis of the five groups in all the tested hours indicated a significant difference between the two control and hydrogel groups with the other three groups at the level of p < 0.01.
 Based on the analysis, it was found that phage 4 is significant with all other weeks of the phage group (p < 0.001).
Based on the analysis, it was found that phage 4 is significant with all other weeks of the phage group (p < 0.001).  indicates that the phage–antibiotic 8 is significant with the other weeks of the phage–antibiotic group at the p < 0.001 level.
indicates that the phage–antibiotic 8 is significant with the other weeks of the phage–antibiotic group at the p < 0.001 level.
 Based on the analysis, it was found that phage 4 is significant with all other weeks of the phage group (p < 0.001).
Based on the analysis, it was found that phage 4 is significant with all other weeks of the phage group (p < 0.001).  indicates that the phage–antibiotic 8 is significant with the other weeks of the phage–antibiotic group at the p < 0.001 level.
indicates that the phage–antibiotic 8 is significant with the other weeks of the phage–antibiotic group at the p < 0.001 level.


 indicates that the wound size of group AO was significantly different from those of groups PD and PAD on day 3 of the treatment (p < 0.05).
indicates that the wound size of group AO was significantly different from those of groups PD and PAD on day 3 of the treatment (p < 0.05).  indicates that on day 7 of the treatment, the wound size of the AO group was significantly different to those of the PD, PAD and PAO groups (p < 0.01).
indicates that on day 7 of the treatment, the wound size of the AO group was significantly different to those of the PD, PAD and PAO groups (p < 0.01).  indicates that the wound sizes of groups C and PD were significantly different on day 10 of the treatment (p < 0.01).
indicates that the wound sizes of groups C and PD were significantly different on day 10 of the treatment (p < 0.01).  Based on the analysis, the wound size of the group C was significantly different from those of groups AD, PAD and PD, and the wound size of group AO was significantly different from those of groups PD and PAO on day 14 of the treatment (p < 0.01).
Based on the analysis, the wound size of the group C was significantly different from those of groups AD, PAD and PD, and the wound size of group AO was significantly different from those of groups PD and PAO on day 14 of the treatment (p < 0.01).
 indicates that the wound size of group AO was significantly different from those of groups PD and PAD on day 3 of the treatment (p < 0.05).
indicates that the wound size of group AO was significantly different from those of groups PD and PAD on day 3 of the treatment (p < 0.05).  indicates that on day 7 of the treatment, the wound size of the AO group was significantly different to those of the PD, PAD and PAO groups (p < 0.01).
indicates that on day 7 of the treatment, the wound size of the AO group was significantly different to those of the PD, PAD and PAO groups (p < 0.01).  indicates that the wound sizes of groups C and PD were significantly different on day 10 of the treatment (p < 0.01).
indicates that the wound sizes of groups C and PD were significantly different on day 10 of the treatment (p < 0.01).  Based on the analysis, the wound size of the group C was significantly different from those of groups AD, PAD and PD, and the wound size of group AO was significantly different from those of groups PD and PAO on day 14 of the treatment (p < 0.01).
Based on the analysis, the wound size of the group C was significantly different from those of groups AD, PAD and PD, and the wound size of group AO was significantly different from those of groups PD and PAO on day 14 of the treatment (p < 0.01).

| Ps15 | Ps14 | Ps13 | Ps12 | Ps11 | Ps10 | Ps9 | Ps8 | Ps7 | Ps6 | Ps5 | Ps4 | Ps3 | Ps2 | Ps1 | |
|---|---|---|---|---|---|---|---|---|---|---|---|---|---|---|---|
| - | (+) | - | - | ++ | - | - | (+) | ++ | (+) | (+) | + | - | - | + | PA25 |
| - | + | - | - | ++ | + | + | + | + | ++ | ++ | + | - | - | - | PA19 |
| - | + | - | - | ++ | - | (+) | - | - | ++ | ++ | - | - | - | + | PB9 |
| + | + | - | ++ | ++ | - | - | - | + | ++ | ++ | + | + | ++ | + | PB10 |
| - | + | - | - | ++ | (+) | (+) | - | + | ++ | ++ | + | - | - | (+) | PA24 |
| - | (+) | - | - | ++ | - | ++ | - | (++) | (++) | ++ | (+) | + | - | + | PA13 |
| - | (+) | - | - | ++ | - | + | - | ++ | - | ++ | + | - | - | - | PC8 |
| - | - | - | - | ++ | - | + | - | ++ | - | ++ | + | - | - | - | PC5 |
| - | + | - | - | ++ | - | + | - | - | ++ | ++ | (+) | + | - | (+) | PC4 |
| - | - | - | - | ++ | - | (+) | - | ++ | - | ++ | + | - | - | + | PC2 |
Disclaimer/Publisher’s Note: The statements, opinions and data contained in all publications are solely those of the individual author(s) and contributor(s) and not of MDPI and/or the editor(s). MDPI and/or the editor(s) disclaim responsibility for any injury to people or property resulting from any ideas, methods, instructions or products referred to in the content. |
© 2023 by the authors. Licensee MDPI, Basel, Switzerland. This article is an open access article distributed under the terms and conditions of the Creative Commons Attribution (CC BY) license (https://creativecommons.org/licenses/by/4.0/).
Share and Cite
Shafigh Kheljan, F.; Sheikhzadeh Hesari, F.; Aminifazl, M.S.; Skurnik, M.; Goladze, S.; Zarrini, G. Design of Phage-Cocktail–Containing Hydrogel for the Treatment of Pseudomonas aeruginosa–Infected Wounds. Viruses 2023, 15, 803. https://doi.org/10.3390/v15030803
Shafigh Kheljan F, Sheikhzadeh Hesari F, Aminifazl MS, Skurnik M, Goladze S, Zarrini G. Design of Phage-Cocktail–Containing Hydrogel for the Treatment of Pseudomonas aeruginosa–Infected Wounds. Viruses. 2023; 15(3):803. https://doi.org/10.3390/v15030803
Chicago/Turabian StyleShafigh Kheljan, Fatemeh, Farzam Sheikhzadeh Hesari, Mohammad Sadegh Aminifazl, Mikael Skurnik, Sophia Goladze, and Gholamreza Zarrini. 2023. "Design of Phage-Cocktail–Containing Hydrogel for the Treatment of Pseudomonas aeruginosa–Infected Wounds" Viruses 15, no. 3: 803. https://doi.org/10.3390/v15030803
APA StyleShafigh Kheljan, F., Sheikhzadeh Hesari, F., Aminifazl, M. S., Skurnik, M., Goladze, S., & Zarrini, G. (2023). Design of Phage-Cocktail–Containing Hydrogel for the Treatment of Pseudomonas aeruginosa–Infected Wounds. Viruses, 15(3), 803. https://doi.org/10.3390/v15030803







